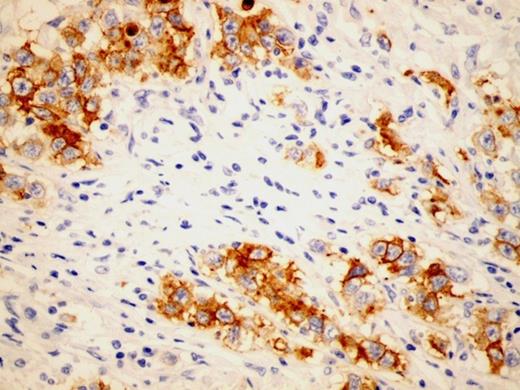
PLAP positive tumour cells (X200)

-
PDF
- Split View
-
Views
-
Cite
Cite
A Yılmaz, B Bayraktar, J Sagiroglu, B Gucluer, Giant seminoma in an undescended testis presenting as an abdominal wall mass, Journal of Surgical Case Reports, Volume 2011, Issue 12, December 2011, Page 9, https://doi.org/10.1093/jscr/2011.12.9
Close - Share Icon Share
Abstract
Seminomas in undescended testes may present as abdominal wall tumours. A unilateral testis tumour in a 29 year old man with ipsilateral undescended testis is presented and relevant literature is reviewed.
A 29 year old man presenting with a tender left lower abdominal mass was admitted to our clinic and initial diagnostic tests followed by abdominal computerized tomography (CT) and positron emission tomography/computerized tomography (PET/CT) were performed. Abdominal CT clearly demonstrated the tumour location between the lower left abdominal subcutaneous layer and the external oblique fascia. He underwent surgery and the tumour was resected via en-bloc excision.
Pathological diagnosis of the resected specimen was consistent with classical seminoma and no distant metastasis was detected with PET/CT. He was referred to oncology clinic after discharge.
Tumours of undescended testis can present as an abdominal wall mass and clinicians must be aware of their existence.
INTRODUCTION
Undescended testes carry a higher potential for malignant transformation than normally descended testis. Seminoma is the most frequent carcinoma of the testicle in the fourth decade of life and constitutes 60% to 65% of germ cell neoplasias. Several histopathological characteristics of the tumour have been evaluated and three types of pure seminoma have been described: classic, anaplastic and spermatocytic.
We report a patient with seminoma arising in an undescended testis which presented as a palpable painful mass of lower abdomen.
CASE REPORT
A 29 year old man with no known previous complaint presented with 4 month history of progressively enlarging mass on his left lower abdomen. The mass was slightly tender and located immediately above the left groin (Figure 1). This was thought to be a soft tissue sarcoma. CT scan revealed a mass of 21×13×11 cm located between the abdominal subcutaneous and external oblique fascial layers. PET CT was performed and no evidence of distant metastatic disease was detected. Fine needle aspiration or percutaneous biopsy was not performed.

He underwent surgery and en-bloc resection of the tumour via a left oblique flank incision was performed (Figure 2). The tumour was completely resected within generous margins of normal tissue.

The specimen demonstrated typical characteristics of classical seminoma with a smoothly demarcated fibrous capsule, which had a vascularized outer surface, and some spermatic chord structures were also identified macroscopically.
Immunohistochemistry studies revealed PLAP (plasental alchaline phosphatase) positive (Figure 3), p53 positive and CD45 negative tumour cells. Epididym and spermatic chord were not invaded. Tunica vaginalis was intact, however, the tunica vasculosa that was located under tunica albuginea nested tumour cell piles (positive lymphovascular invasion).
He was referred to oncology clinic after discharge.
DISCUSSION
Germ cell tumours (GCT) of testes can be benign (teratomas) or malignant (seminoma and non-seminoma). GCT most frequently occur in the gonads, only 2-5% of them arise in extragonadal regions such as the mediastinum, retroperitoneum, pineal gland and sacral area (1). Seminoma is the most common single histologic type of germinal testicular neoplasms. The undescended testicles carry 20-48 times higher potential for malignant transformation than the normally descended testicles (2). Testicular ectopia is uncommon and the most frequent ectopic location of testis are superficial inguinal pouch, infront and lateral to the external inguinal ring and very rarely in the abdomen (3). The position of the undescended testis is related to the likelihood of carcinogenesis with intra-abdominal testis having the highest malignant potential. The majority of undescended testes locate distal to the external inguinal ring and are palpable (2).
Exogenous estrogen administration to the mother during pregnancyhas been associated with an increased relative risk for testicular tumours in the fetus, ranging from 2.8 to 5.3 over the expected incidence. Other acquired factors such as trauma and infection-related testicular atrophy have been associated with testicular tumours; however, a causal relationship has not been established.
Our patient had his right testis in the scrotum and there was no palpable testis in the left scrotum. This rapidly enlarging tumour was detected in the region betwen the external oblique fascia and the abdominal subcutaneous layer, distal to the external inguinal ring (Figure 4). He was the father of a healthy 18 month-old son. Exogenous estrogen administration to his mother during pregnancywas not reported.

Approximately 7-10% of testicular tumours develop in patients who have a history of cryptorchidism; seminoma is the most common form of tumour these patients have. However, 5-10% of testicular tumours occur in the contralateral, normally descended testis. The relative risk of malignancy is highest for the intra-abdominal testis (5%) and is significantly lower for the inguinal testis (1.25%) (4). Orchiopexy does not alter the malignant potential of the cryptorchid testis; however, it facilitates examination and tumour detection (5).
Three clinical stages for the determination of the extension of the tumour have been described. Stage I is where the tumour is limited to the testis with or without invasion of epididymis or the spermatic cord. In Stage II the tumour has retroperitoneal lymph node metastases. Stage III tumour has distant metastases.
The germ cell tumour often gives lymph node metastasis, except from choriocarcinoma, which is characterized by early hematogenous spread. Age, tumour size, lymphovascular invasion, mitotic count, necrosis, percent of giant cell and tumour infiltrating lymphocytes are possible prognostic factors in the treatment of seminomas.
In this particular case, the tumour was classified as Stage I classical seminoma with positive lymphovascular invasion (tunica vasculosa nested tumour cells).
Unilateral rapidly enlarging tender abdominal wall mass with undescended testis should alert clinicians towards consideration of the possibility of seminoma and initiation of prompt intervention.